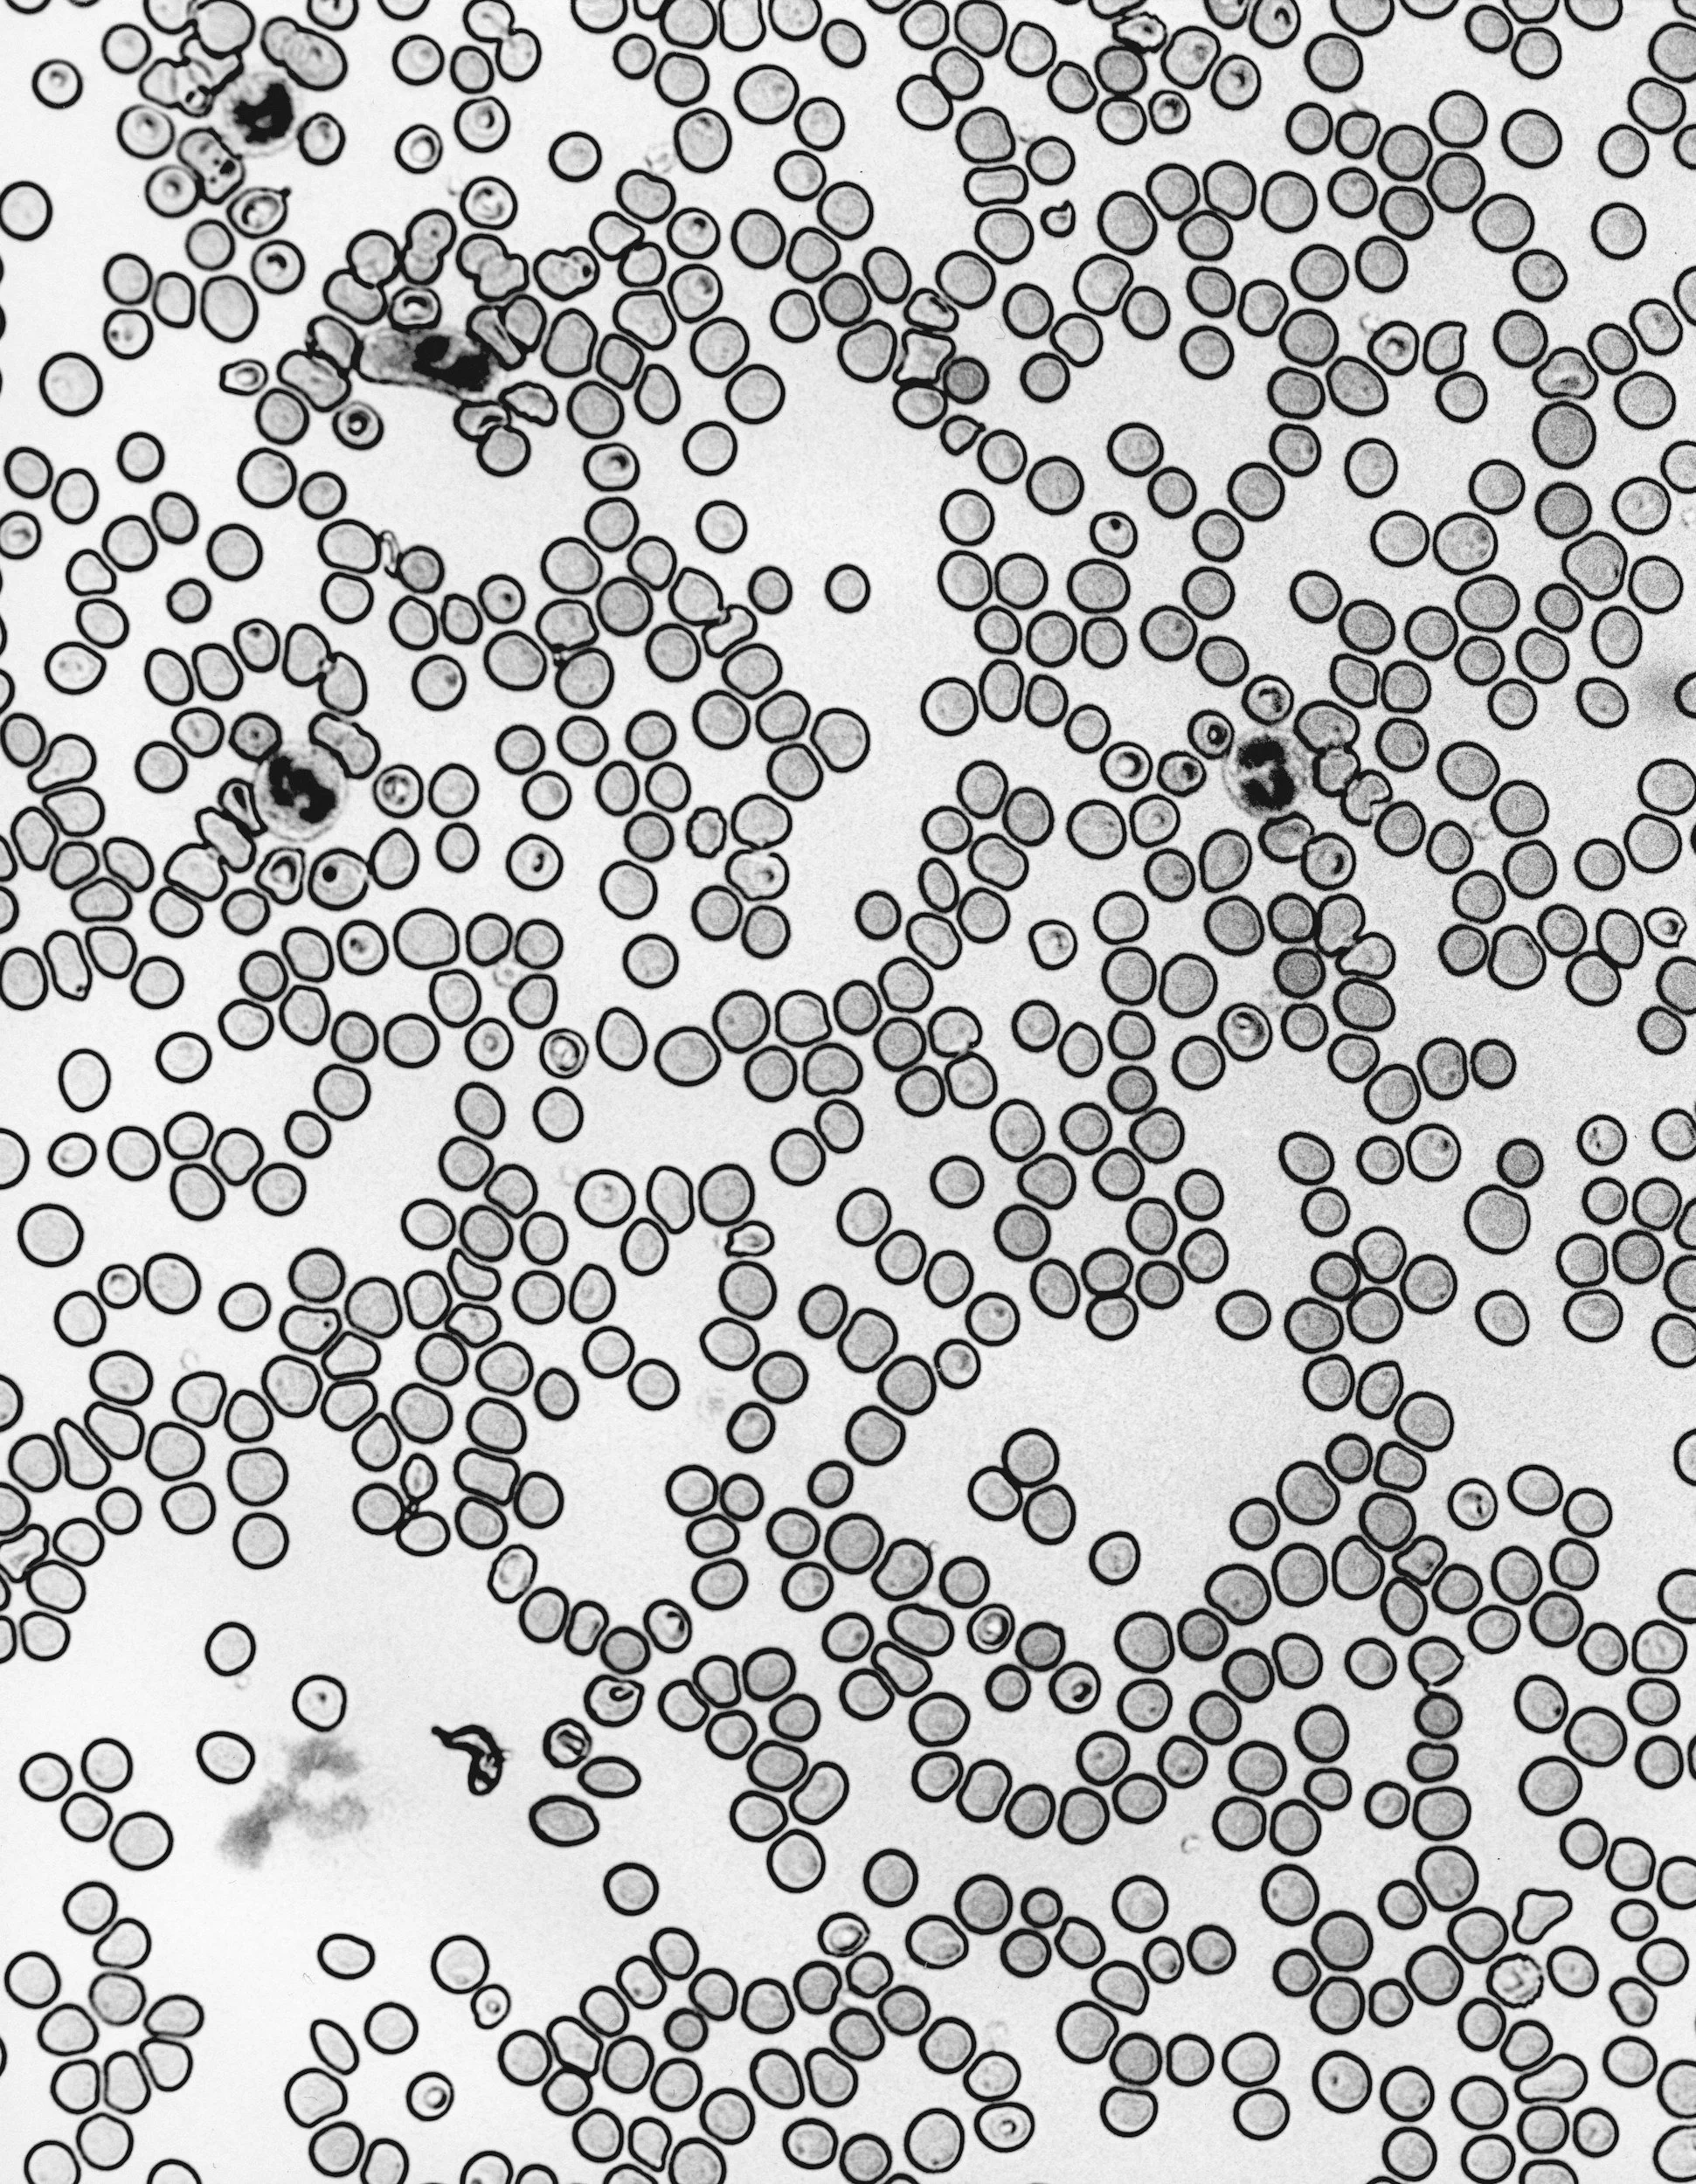

-
![Microscopic view of numerous red blood cells, some of which are in clusters and irregular shapes, with a few dark spots and debris scattered throughout.]()
Orthobiologics
Evidence-based spectrum of orthobiologic treatments including PRP, PPP, MFAT, and BMAC
-
![Close-up of splashing water in a natural stream or river.]()
Tenjet
For chronic tendon pain that just won’t quit
-
![A wireframe sculpture of a human figure with purple neon lights, sitting with head bowed against a dark background.]()
Nerve Entrapments
Targeted ultrasound-guided procedures and hydrodissections to free up compressed or irritated nerves
-
![Frozen icicles and ice formations around trees and bushes in a winter landscape.]()
Adhesive Capsulitis
Ultrasound-guided capsular distension procedures
-
![A woman sitting on a bed, touching her knee with her hand, wearing a floral-patterned dress.]()
Osteoarthritis
Variety of treatment strategies for all of your degenerative joints
-
![An anatomical illustration of the human digestive system, showing the stomach, small intestine, and large intestine from two different angles.]()
Inflammatory Bowel Disease
Evaluation for primary orthopedic issue or is it stemming from other chronic disease